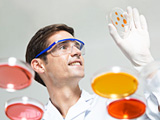

全国统一服务热线:400-7751251
电话: 010-56459060-801
邮箱 :sy@cojato.com
地址:北京市通州区新华大街北京ONE国际广场2704-2705室 |
|
|
|
| 公司优势 |
 您的当前位置:首页 > 公司优势 您的当前位置:首页 > 公司优势 |
 |
| 我们聘请数位行业内具有广泛影响力的专家教授组成了强大的专家顾问团,为产品的整个实施过程提供充分、权威的论证。 |
|
|
| 项目操作及管理全程实施标准化规范的操作流程(SOP),严格遵守国家各项政策法规要求。项目经过调研、立项、策划、论证,设计可实施的操作方案。项目实施过程中进行全方位监测,协调与风险控制。 |
|
 |
| 完整的质量控制体系,严谨、标准、系统的操作规程。保证管理体系有法可依、有据可查。 |
|
 |
| 我们拥有完善、严格的保密制度,为您产品的知识产权保驾护航。 |
|
 |
| 为企业提供专业高效的服务品质,推进产品市场化进程,诚实守信,成为企业值得信赖的战略合作伙伴。 |
|
|
|